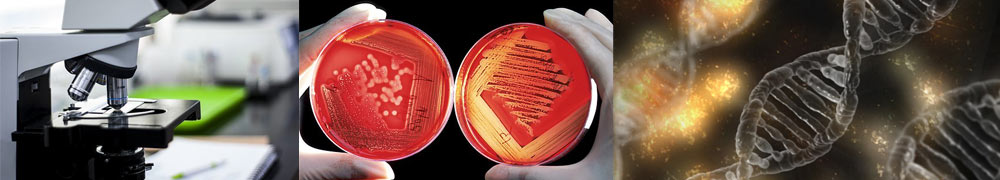

È online il sito della biobanca dell’ENEA, una grande raccolta di microrganismi composta da oltre 1400 tra batteri, funghi, lieviti, microalghe e virus vegetali, utili per molteplici applicazioni in settori quali agricoltura, ambiente, beni culturali, bioenergia, qualità e sicurezza alimentare, salute.

Conservate nei quattro Centri Ricerche ENEA di Brindisi, Casaccia (Roma), Portici (Napoli) e Trisaia (Matera), le risorse microbiche sono state catalogate e, nel corso degli anni, sono state caratterizzate, arrivando a costituire un patrimonio unico a livello nazionale. Il ruolo fondamentale svolto dai microorganismi nel mantenimento della vita sulla terra è indiscusso. I possibili utilizzi sono innumerevoli: dai microrganismi, infatti, possono essere prodotti biopesticidi, biofertilizzanti, biomasse, enzimi industriali e antimicrobici utili, ad esempio, per la costituzione di consorzi microbici per l’agricoltura sostenibile, per la produzione di alimenti fermentati, di nuovi superfood e di cibi funzionali, nei processi di biorisanamento e per la produzione di biocarburanti e nuovi biomateriali, a sostegno del “Made in Italy”.
Le comunità microbiche, infatti, non solo sono in grado di colonizzare gli ambienti più diversi, ma sono anche capaci di adattarsi ai cambiamenti, anche drastici, che avvengono nell’ambiente che esse occupano. I microrganismi hanno anche un ruolo importante negli ecosistemi come decompositori, in quanto capaci di trasformare la sostanza organica morta (saprofiti) in sostanza inorganica, utile alle piante per vivere. Alcune specie di batteri e funghi in particolare sono utilizzati proprio come biostimolanti, in quanto promotori della crescita delle piante. Nello specifico, questi microrganismi agiscono producendo una serie di enzimi utili alla pianta e stimolandone le difese endogene. I benefici dei microrganismi si estendono poi anche alla qualità del terreno. Questi hanno infatti il merito di creare nella rizosfera (la parte del terreno più prossima alle radici), condizioni ottimali affinché la pianta assimili più rapidamente le sostanze nutritive di cui ha bisogno. Alcuni di essi, inoltre, sono capaci di rendere nuovamente disponibile il fosforo insolubile e il ferro indisponibile (siderofori).
La collezione microbica ENEA, infatti, comprende microrganismi con attività di promozione della crescita delle piante e di biocontrollo di funghi fitopatogeni, adattati ad ambienti estremi, con applicazioni biotecnologiche, nonché impiegabili per la produzione di molecole bio-based nei settori nutraceutico, cosmeceutico e farmaceutico, per la chimica verde, il biorisanamento, il biorestauro e la biomedicina. Facilmente consultabile attraverso l’utilizzo di alcune chiavi di ricerca che consentono di filtrare i dati desiderati, il database fornisce informazioni riguardanti il microrganismo, la sua assegnazione tassonomica, origine e geolocalizzazione geografica, condizioni di crescita e campi di applicazione, associati ai riferimenti bibliografici che riportano ulteriori informazioni relative ai ceppi e al loro utilizzo.
Annamaria Bevivino, curatrice della collezione: “La collezione microbica ENEA rappresenta uno strumento di eccellenza per la salvaguardia della biodiversità microbica e per lo sviluppo della bioeconomia circolare e della biosostenibilità. Le risorse biologiche (microrganismi, microbiomi e loro derivati) sono cruciali per il progresso delle biotecnologie, della salute umana, dei sistemi agricoli e alimentari e per la ricerca e lo sviluppo delle scienze della vita e della bioindustria”.
—————————————————————————-
I ceppi batterici della collezione appartengono ai generi Burkholderia, Pseudomonas, Bacillus, Arthrobacter, Streptomyces, Paenibacillus, Staphylococcus, Stenotrophomonas e Microbacterium; per i funghi Aspergillus, Penicillium, Engyodontium, Cladosporium e Trichoderma, e per i lieviti Saccharomyces, Rhodotorula e Pichia. Sono anche presenti le specie di microalghe Haematococcus pluvialis e Scenedesmus almeriensis e un virus vegetale, il Potexvirus, con importanti applicazioni biotecnologiche.
——————————————————————————————————————————————————————–
La costituzione della collezione microbica ENEA, organizzata secondo procedure operative e standard di qualità, permette di rafforzare la rete nazionale delle biobanche di microrganismi e conservare e valorizzare la biodiversità̀ microbica, mettendo a disposizione strumenti efficaci per affrontare sfide sociali, economiche e ambientali. La piattaforma digitale del database ENEA sarà integrata nel catalogo nazionale delle collezioni microbiche al fine di istituire una piattaforma unica per la promozione di risorse, servizi, tecnologie, competenze e attività di trasferimento tecnologico.
RELOADER onlus
28 aprile 2024
Innovazione